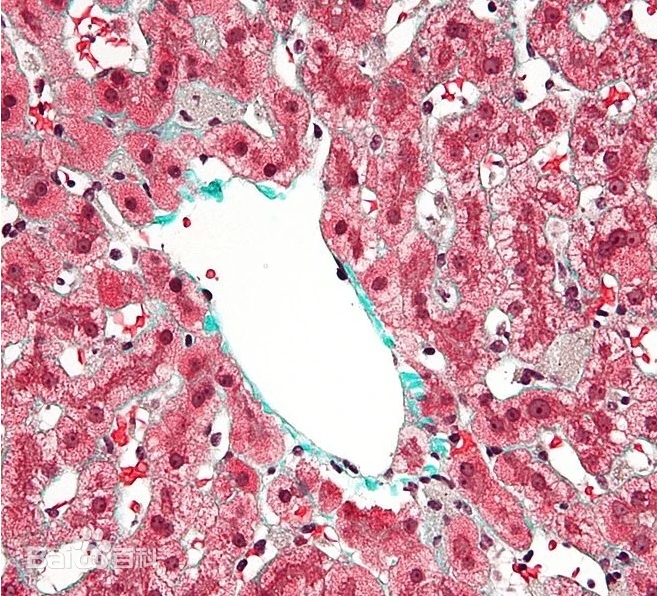
产品细节图片1

相关产品推荐更多 >
万千商家帮你免费找货
0 人在求购买到急需产品
- 详细信息
- 文献和实验
- 技术资料
- 库存:
100
- 英文名:
Monkey hepatic kupffer cells
- CAS号:
无
- 保质期:
2年
- 供应商:
汇智和源
- 保存条件:
液氮
- 规格:
元
产品介绍
库普弗细胞(Kupffer cell、Browicz-Kupffer cell、stellate macrophages,亦称为肝巨噬细胞)是位于肝脏中的特殊巨噬细胞,是单核吞噬细胞系统(mononuclear phagocyte system)的一部分。由血液单核细胞黏附于肝窦壁上分化而成,可通过吞噬作用清除血循环中异物颗粒或红细胞。肝纤维化过程中,可见kupffer细胞的增生。
相关产品
|
类别 |
名称 |
|
肝星状细胞 |
食蟹猴肝星状细胞 Monkey hepatic stellate cells |
|
比格犬肝星状细胞 Beagle Dog hepatic stellate cells | |
|
大鼠肝星状细胞 Rat hepatic stellate cells | |
|
小鼠肝星状细胞 Mouse hepatic stellate cells | |
|
小型猪肝星状细胞 Minipig hepatic stellate cells | |
|
肝库普弗细胞 |
食蟹猴肝库普弗细胞 Monkey hepatic kupffer cells |
|
比格犬肝库普弗细胞 Beagle Dog hepatic kupffer cells | |
|
大鼠肝库普弗细胞 Rat hepatic kupffer cells | |
|
小鼠肝库普弗细胞 Mouse hepatic kupffer cells | |
|
小型猪肝库普弗细胞 Minipig hepatic kupffer cells | |
|
肝窦内皮细胞 |
食蟹猴肝窦内皮细胞 Monkey sinusoidal endothelial cells |
|
比格犬肝窦内皮细胞 Beagle Dog sinusoidal endothelial cells | |
|
大鼠肝窦内皮细胞 Rat sinusoidal endothelial cells | |
|
小鼠肝窦内皮细胞 Mouse sinusoidal endothelial cells | |
|
小型猪肝窦内皮细胞 Minipig sinusoidal endothelial cells | |
|
食蟹猴肝非实质细胞 Monkey liver non parenchymal cells | |
|
比格犬肝非实质细胞 Beagle Dog liver non parenchymal cells | |
|
大鼠肝非实质细胞 Rat liver non parenchymal cells | |
|
小鼠肝非实质细胞 Mouse liver non parenchymal cells | |
|
肾近端小管上皮细胞 |
食蟹猴肾近端小管上皮细胞 Monkey Kidney Proximal Tubule Cells |
|
比格犬肾近端小管上皮细胞 Beagle Dog Kidney Proximal Tubule Cells | |
|
大鼠肾近端小管上皮细胞 Rat Kidney Proximal Tubule Cells | |
|
小鼠肾近端小管上皮细胞 Mouse Kidney Proximal Tubule Cells | |
|
小型猪肾近端小管上皮细胞 Minipig Kidney Proximal Tubule Cells | |
|
肾皮质上皮细胞 |
食蟹猴肾皮质上皮细胞 Monkey HRCEpiC |
|
比格犬肾皮质上皮细胞 Beagle Dog HRCEpiC | |
|
大鼠肾皮质上皮细胞 Rat HRCEpiC | |
|
小鼠肾皮质上皮细胞 Mouse HRCEpiC | |
|
小型猪肾皮质上皮细胞 Minipig HRCEpiC | |
|
结肠上皮细胞 |
食蟹猴结肠上皮细胞 Monkey Colonic epithelial cell |
|
比格犬结肠上皮细胞 Beagle Dog Colonic epithelial cell | |
|
大鼠结肠上皮细胞 Rat Colonic epithelial cell | |
|
小鼠结肠上皮细胞 Mouse Colonic epithelial cell | |
|
小型猪结肠上皮细胞 Minipig Colonic epithelial cell | |
|
脂肪前体细胞 |
人皮下脂肪前体细胞 Human subcutaneous adipose tissue precursor cells |
|
人内脏脂肪前体细胞 Human visceral adipose tissue precursor cells | |
|
小型猪皮下脂肪前体细胞 Minipig subcutaneous adipose tissue precursor cells | |
|
小型猪内脏脂肪前体细胞 Minipig visceral adipose tissue precursor cells | |
|
皮肤细胞 |
人皮肤成纤维细胞 Human Dermal Fibroblast |
|
人表皮角质形成细胞 Human epidermal keratinocytes | |
|
人表皮黑色素细胞 Human epidermal melanocytes |
其他ADME产品
原代肝细胞 Hepatocytes :人、猴、犬、大鼠、小鼠、猪等(贴壁/悬浮)
肝微粒体 Liver Microsomes :人、猴、犬、大鼠、小鼠、猪、兔、猫、羊、牛、鸡、鸭等
肠微粒体 Intestinal Microsomes :人、猴、犬、大鼠、小鼠、猪等
肺微粒体 Lung Microsomes :人、猴、犬、大鼠、小鼠
肾微粒体 Kidney Microsomes :人、猴、犬、大鼠、小鼠
皮肤微粒体 Skin Microsomes :人、猴、犬、大鼠、小鼠
S9 Fraction :肝、肠、肺、肾、皮肤(人、猴、犬、大鼠、小鼠等)
胞质液/Cytosol :肝、肠、肺、肾、皮肤(人、猴、犬、大鼠、小鼠等)
重组酶CYP酶/CYP450酶:重组人CYP1A1酶、重组人CYP1A2酶、重组人CYP2A6酶、重组人CYP2B6酶、重组人CYP2C8酶、重组人CYP2C9酶、重组人CYP2C19酶、重组人CYP2D6酶、重组人CYP2E1酶、重组人CYP3A4酶、重组人CYP3A5酶
重组UGT酶/UGT酶:重组人UGT1A1酶、重组人UGT1A3酶、重组人UGT1A4酶、重组人UGT1A6酶、重组人UGT1A7酶、重组人UGT1A8酶、重组人UGT1A9酶、重组人UGT1A10酶、重组人UGT2B7酶、重组人UGT2B15酶、重组人UGT2B17酶
ABC转运体:MDR1(P-gp)、BCRP、BSEP、MRP1、MRP2、MRP3、MRP4等
血浆蛋白结合试验专用血浆 PPB Plasma :人、猴、犬、大鼠、小鼠
血浆稳定性试验专用血浆 Stability Plasma :人、猴、犬、大鼠、小鼠
体外代谢标准品
探针底物: 氯唑沙宗、甲苯磺丁脲、奥美拉唑、非那西丁、睾丸酮、香豆素、美芬妥因
探针底物代谢物: 1-羟基米达唑仑、对乙酰氨基酚、4-羟基甲苯磺丁脲、右啡烷、5-羟基奥美拉唑、6-羟基氯唑沙宗、6β-羟基睾丸酮、7-羟基香豆素、4-羟基美芬妥因
抑制剂: α-萘黄酮、毛果云香碱、磺胺苯吡唑、噻氯匹定、奎尼丁、二乙基二硫代氨基甲酸钠、酮康唑

ADME服务
肝微粒体代谢稳定性(人,猴,犬,大鼠,小鼠)
肝细胞代谢稳定性试验(人,猴,犬,大鼠,小鼠)
代谢表型研究 :重组酶法/化学抑制法
CYP450酶:CYP1A2,CYP2A6,CYP2B6,CYP2C8,CYP2C9,CYP2C19,CYP2D6,CYP2E1,CYP3A4等
UGT酶:UGT1A1、UGT1A3、UGT1A4、UGT1A6、UGT1A7、UGT1A8、UGT1A9、
UGT1A10、UGT2B7、UGT2B15、UGT2B17等
代谢产物鉴定/代谢途径鉴定(人,猴,犬,大鼠,小鼠)
CYP450抑制实验:CYP1A2,CYP2A6,CYP2B6,CYP2C8,CYP2C9,CYP2C19,CYP2D6,CYP2E1,CYP3A4等
酶诱导试验:原代肝细胞——CYP1A2、CYP2B6、CYP3A43、CYP2C
血浆蛋白结合率(PPB)测定:平衡透析法/超滤法/超速离心法
血浆稳定性试验
SLC转运体研究:OATP1B1、OATP1B3、OAT1、OAT3、OCT2、MATE1、MATE2-K
ABC转运体研究:MDR1(P-gp)、BCRP、BSEP、MRP1、MRP2、MRP3、MRP4等

风险提示:丁香通仅作为第三方平台,为商家信息发布提供平台空间。用户咨询产品时请注意保护个人信息及财产安全,合理判断,谨慎选购商品,商家和用户对交易行为负责。对于医疗器械类产品,请先查证核实企业经营资质和医疗器械产品注册证情况。
文献和实验
IPHASE/汇智和源作为体外研究生物试剂引领者,推出了多领域、多种类的高端科研试剂,为药物早期研发提供筛选工具,为生命科学领域的探索提供新材料、新方法和新手段,为遗传毒性研究提供便捷产品。
因子Ⅱ活性正常或轻度下降;慢性肝炎中度、重度和肝硬化患者,凝血因子Ⅱ活性水平明显下降,说明它的降低程度与肝细胞损害程度密切相关。 研究显示凝血因子Ⅴ活性在肝功能失代偿或严重肝病时才减少,故认为它是判断肝病患者预后的良好指标。Izumi等研究显示:对乙酰氨基酚诱导的需肝移植的暴发性肝功能衰竭患者,凝血因子Ⅴ活性 凝血因子Ⅷ不仅由肝细胞产生,而且由窦内皮细胞与库普弗细胞产生,其它组织如肾脏也可产生。当肝细胞合成功能减退时,窦内皮细胞及库普弗细胞仍维持凝血因子Ⅷ
的嗅脑不很发达,嗅觉不很灵敏,而听觉敏感,有发达的触觉和味觉。 8.猴为单室胃,胃液呈中性,含0.01~0.043%的游离盐酸,肠子的长度与体长的比例为5:1-8:1,猴的盲肠很发达,但无蚓 。猕猴都有胆囊,位于肝脏的右中央叶,肝分6叶。 猴肺为不成对肺叶,右肺3~4叶,左肺2~3叶。猴的血液循环系统和人一样。 9.猕猴的血型有A、B、O型和Lewis型、MN型、Rh型、Hr型等。猕猴血型和人的A、B、O、Rh型相同。恒河猴主要是B型;食蟹猴主要是B、A、AB型,O型较少
都很强,对周围发生的一切事情都感染兴趣。 猴的视觉较人类敏感,猴的视膜具有黄斑,有中央凹。视网膜黄斑除有和人类相似的锥体细胞外,还有杆状细胞。猴有立体感,能辨别物体的形状和空间位置,有色觉,能辨别各种颜色,并有双目视力。猴的嗅脑不很发达,嗅觉不很灵敏,而听觉敏感,有发达的触觉和味觉。 8.猴为单室胃,胃液呈中性,含0.01~0.043%的游离盐酸,肠子的长度与体长的比例为5:1-8:1,猴的盲肠很发达,但无蚓 。猕猴都有胆囊,位于肝脏的右中央叶,肝分6叶。
技术资料








